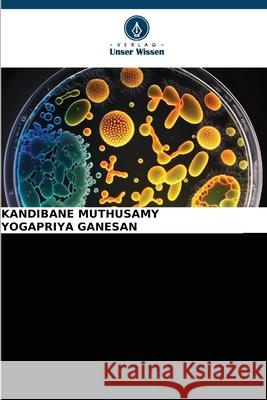
AKTUELLE FORTSCHRITTE bei Bacillus thuringiensis Muthusamy, Kandibane, GANESAN, YOGAPRIYA 9786202195348 Verlag Unser Wissen - książka

AKTUELLE FORTSCHRITTE bei Bacillus thuringiensis » książka
AKTUELLE FORTSCHRITTE bei Bacillus thuringiensis
ISBN-13: 9786202195348 / Niemiecki / Miękka / 2025 / 100 str.
Bacillus thuringiensis (B.t.) ist ein gram-positives Bodenbakterium, das als eines der Entomopathogene zur Bekämpfung von Lepidoptera-Schädlingen auf Feldern und in Gartenbaukulturen eingesetzt wird. Die verschiedenen Formulierungen von B.t. wurden erfolgreich eingesetzt, um die Umwelt und Lebensmittel vor der Kontamination durch chemische Pestizidrückstände in der Schädlingsbekämpfung zu schützen. Die Entdeckung von B.t. -Toxinen mit neuartiger insektizider Wirkung gegen Schädlinge und die Entwicklung gentechnisch veränderter Pflanzen eröffnete eine neue Ära der Schädlingsbekämpfung. Transgene B.t. -Pflanzen, darunter Mais, Baumwolle und Sojabohnen, wurden inzwischen produziert und vermarktet, um Nutzpflanzen vor etwa 30 wichtigen Coleoptera- und Lepidoptera-Schädlingen zu schützen, was der Umwelt und der Wirtschaft sehr zugute kommt. Mit dem langfristigen Anbau von B.t. -Pflanzen haben einige der Zielschädlinge jedoch allmählich eine Resistenz entwickelt. Zahlreiche Studien haben gezeigt, dass Mutationen in Genen für die Aktivierung von Toxinen, die Bindung von Toxinen und die Immunisierung von Insekten wichtige Ursachen für die B.t.-Resistenz sind. Eine eingehende Untersuchung der entsprechenden Resistenzmechanismen von B.t. wird bei der Entwicklung neuer Strategien zur Vorbeugung und Bekämpfung von Schädlingen helfen.